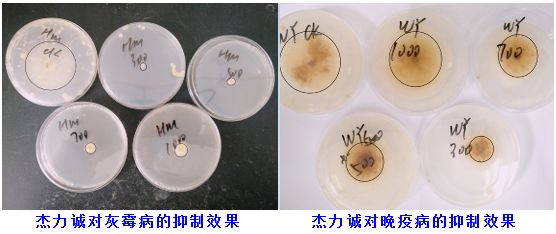
鍐滅敤楂樼鍔╁墏,缇庡浗杩堝浘鏉板姏璇氶珮鏁堟鐗╂补鍔╁墏

农药抗性强,农药零增长,需要提高药效;
虫难打,病难治,草难除,需要解决问题;
农药越来越多的套餐销售,需要形成方案;
常规助剂经作易产生药害,需要保证安全。
以上这4大问题, 使得2018年农用植物精油类助剂市场火爆,大家逐步认识到精油类助剂的市场需求,作为全球农化助剂领导企业,迈图集团拥有雄厚的研发实力以及精湛的生产工艺,将精油与增效助剂完美结合,倾力推出了一款全新的环境友好、功能独特、安全高效的植物精油助剂,杰力诚的上市将再一次诠释新一代植物精油助剂的内涵。

关于迈图集团
迈图有70多年助剂的研发和生产历史,是农化助剂行业的领军企业,迈图旗下农化部门拥有丰富的农用助剂产品线,既有超级润湿展扩的有机硅增效剂,也有抗蒸发、抗漂移的航空喷雾助剂、专用消泡剂以及安全高效的植物源增效助剂,精准的助剂定位以及多样化的助剂应用,使得迈图始终走在行业的最前端,迈图品牌和迈图产品得到广大经销商和农民朋友一致认可。
自第一款有机硅喷雾助剂上市以来,迈图的Silwet、AgroSpred系列农用助剂产品已经成为市面上最知名、最受信赖的农用桶混助剂品牌,他们不仅可以改善药剂的展着性和覆盖效果,还能帮助降低制造和运输成本,效果持久稳定,用户遍及70多个国家和地区。
Silwet和AgroSpred系列助剂可以使喷雾药剂更好的覆盖在作物靶标和植物表面,帮助药剂渗透,增加雾滴铺展效果,提高农药利用率,提高药剂的粘着性和耐雨水冲刷性,减少农药的流失和浪费。

禾华农业为迈图精油类农用助剂系列产品的经销商,第一款商业化产品杰力诚即将再全国上市。

杰 力 诚 简 介

杰力诚是迈图最新开发的以高纯度天然橙皮精油为基础,加入独特增效成分的农用助剂,桶混使用能显著提高杀菌剂、杀虫剂、除草剂药效,促进肥料吸收利用,也可作为飞防助剂使用。
杰力诚4大特点
1、杀菌伴侣:杰力诚是杀菌剂的优异伴侣,可快速溶解病菌磷脂层,穿透菌丝体、孢子等,提高对霜霉病、灰霉病、炭疽病、靶斑病等。
2、杀虫增效:杰力诚可加快杀虫剂穿透害虫表皮和溶解蜡质层的速度,提高对飞虱、蓟马、螨类等难防虫害的杀虫效果

3、降低湿度:杰力诚可使叶面表面液滴迅速渗透、蒸发,并在一定时间内保持叶片干燥,降低环境湿度,阻断传播通道,减少病害发生。
4、绿色安全:杰力诚活性成分源于天然橙皮精油,根作物亲和性好,与常规药剂混用安全,对作物生长安全,对环境安全。

杰力诚在飞防中的作用
杰力诚能在飞防喷雾过程中增加雾滴粒径、减少雾滴蒸发、减少药液反弹、加快药液吸收、提高药剂效果,是一款优秀的飞防增效助剂。

杰力诚在冲施中的作用
杰力诚可与杀线剂和冲施肥一起冲施,可与杀线剂和冲施肥组合销售,让药剂和肥料提高杀线虫效果和冲施肥肥效。

杰力诚使用方法
喷雾:稀释使用500-1500倍
飞防:稀释使用100-200倍
冲施:每亩用量300-500ml
杰力诚市场销售及使用案例





杰力诚 ,你值得拥有
招商热线
姜经理 15954275702
▼
长按二维码 关注看更多
在这里
挖掘行业深度
传递行业价值